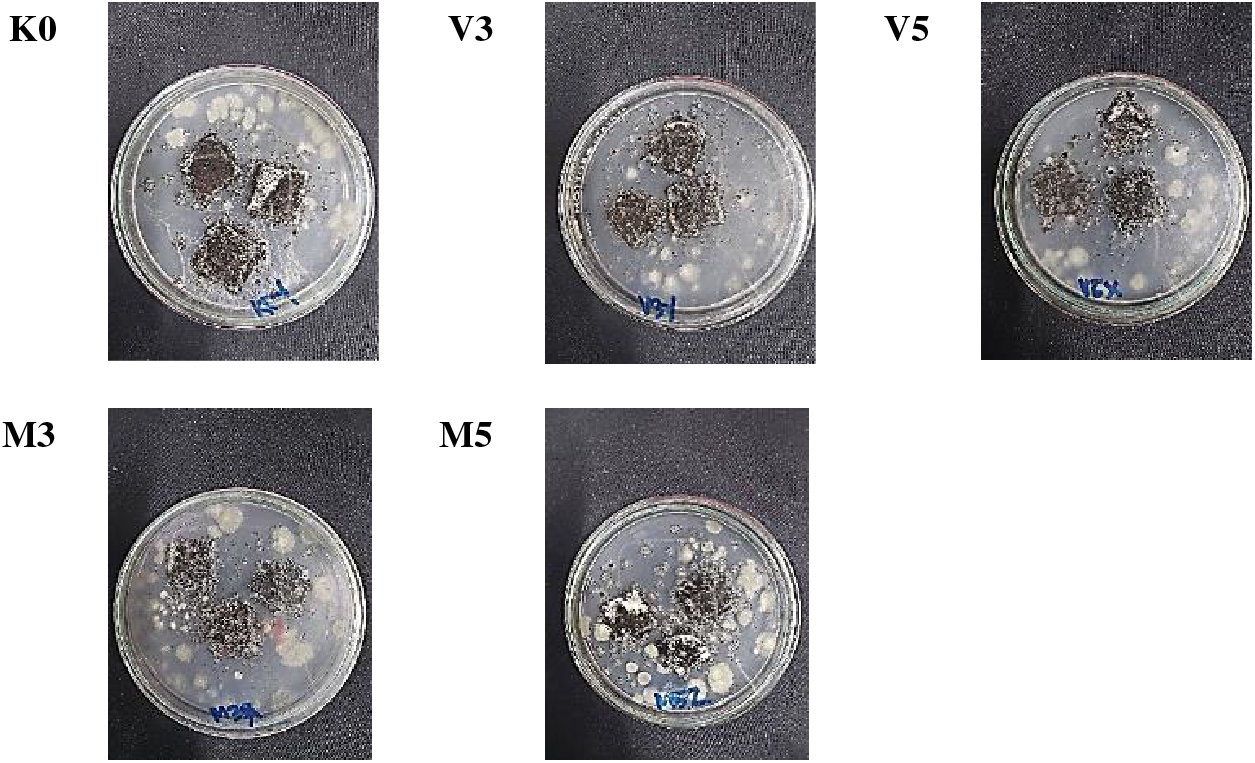
images

Open Access
ARTICLE
Elephant Foot Yam Starch-NCC Bionanocomposite Film Incorporated with Virgin Coconut Oil and Monoglyceride for Hydrophobic and Biodegradable Packaging
1 Departement of Food Industrial Technology, Faculty of Agro-Industrial Technology, Universitas Padjadjaran, Sumedang, 45363, Indonesia
2 Research Center for Biomass and Bioproduct, National Research and Innovation Agency, Cibinong, 40135, Indonesia
* Corresponding Author: Heni Radiani Arifin. Email:
(This article belongs to the Special Issue: Biodegradable Polymer and Biomass Composites)
Journal of Renewable Materials 2025, 13(3), 617-635. https://doi.org/10.32604/jrm.2025.057812
Received 28 August 2024; Accepted 15 January 2025; Issue published 20 March 2025
Abstract
Bionanocomposite film is produced from renewable and biodegradable natural resources. Although elephant foot yam (EFY) starch (Amorphophallus paeoniifolius) is a promising polymer for bionanocomposite film, the native hydrophilic properties influence the overall performance characteristics. Incorporating virgin coconut oil (VCO) and monoglyceride as hydrophobic components can improve mechanical properties and reduce permeability while increasing the hydrophobicity of the composite. Therefore, this study aimed to determine the effect of adding VCO and monoglyceride on EFY starch-nanocrystalline film at 3 and 5 wt% concentrations. Experimental tests were conducted to evaluate the physical and mechanical properties, water vapor transmission rate (WVTR), morphology, functional groups, biodegradability, and hydrophobicity. The results showed that the addition of 5 wt% monoglyceride produced optimum outcomes by reducing the WVTR to 3.99 g.m−2.h−1, increasing the thickness to 0.134 mm and decreasing the solubility to 36.04%. The Universal Testing Machine (UTM) tests showed an elongation of 74.59%, showing excellent elasticity. The Scanning Electron Microscope (SEM) test showed the bonds formed with starch granules, leading to a flatter surface. The Fourier Transform Infrared Spectroscopy (FTIR) test also showed an increase in the wavelength of the C=O groups and a decrease in the O-H groups. The contact angle test processed using image-J showed high hydrophobicity, consequently reducing the biodegradability of bionanocomposite film by the Aspergillus niger fungal degradation test. In conclusion, this study successfully developed bionanocomposite film with enhanced hydrophobicity, elasticity, and barrier properties, highly suitable for protecting food from humid air. The composite holds great potential for further development as an environmentally friendly packaging solution.Graphic Abstract
Keywords
Abbreviation
| VCO | Virgin coconut oil |
| NCC | Nanocrystalline cellulose |
| EFY | Elephant foot yam |
| K0 | 0 wt% lipid |
| V3 | 3 wt% VCO emulsion |
| V5 | 5 wt% VCO emulsion |
| M3 | 3 wt% monoglyceride |
| M5 | 5 wt% monoglyceride |
Conventional plastics made of petroleum oil are easy to find due to the significant function for packaging [1]. Naturally, plastic degradation takes about 300 to 500 years to decompose fully and causes environmental concerns [2]. Microplastic particles often enter the food and beverage chain, which have the potential to carry hazardous chemicals capable of harming human health [3]. Plastic can disrupt the ecosystem by polluting water and the sea, contaminating the soil, and causing soil degradation. Furthermore, plastic production and increasing greenhouse gas emissions worsen the impact of climate change, which further threatens human health and biodiversity. The promising alternative to overcome the concern is a biodegradable film, such as bionanocomposite film, which is easier to decompose [4].
Biodegradable film is increasingly recognized as a sustainable alternative to traditional plastics. Although starch is a prominent biopolymer used in production, several other biopolymers also serve this purpose, such as polylactic acid (PLA) [5], cellulose [6], chitosan [7], and gelatin [8]. One type of biodegradable film is bioplastics such as bionanocomposite film. Starch is a polymer common in bionanocomposite film manufacture because it is abundant in nature, eco-friendly, and easily renewed [9]. Indonesia has abundant types of tubers that can be used as a source of starch including elephant foot yam (EFY), with the amylose content often reaching 28.29% [10]. Despite the potential, the natural starch-based film has several weaknesses, such as low mechanical and hydrophilic properties and low water vapor barrier properties [11]. Therefore, many materials are used in bionanocomposite film to overcome the weakness.
Nanoparticles are fillers that function as reinforcement in biopolymer-based film and otherwise called bionanocomposite [12]. Nanocrystalline cellulose (NCC) is an organic nanoparticle cellulose derivative with a size of about 1 × 10−9 m [13]. It works optimally as a reinforcement due to the larger active area than normal cellulose and a high interaction surface area [14]. This can improve the mechanical and physical properties of bionanocomposite film. However, film reinforced with NCC still improves in certain characteristics, specifically hydrophobic and barrier properties. Bionanocomposite film can be made by solution casting, compression molding, injection casting, and other methods. Solution casting entails printing biopolymer solutions on non-adhesive molds and evaporating solvents to obtain dry and thin bioplastics [15].
Hydrophobic components play a crucial role in improving low water resistance in starch-based bioplastics. Various lipid sources are added to bioplastics due to the ability to increase resistance to water, such as palm oil, virgin coconut oil (VCO), stearic fatty acids, and others [9]. VCO is a vegetable oil containing lauric acid as the main saturated fatty acid composition. Many studies have used VCO as a bioplastic plasticizer, but adding VCO can also affect hydrophobic characteristics [16]. Aside from VCO, monoglyceride has the potential to be a hydrophobic component due to the lipophilic and hydrophilic structure, hence, it does not require an emulsifier to homogenize oil in film.
Previous studies including Arifin et al. (2022) [13] reported that using 5% NCC as a nanofiller in corn starch-based bionanocomposite film increased the tensile strength of film. Fangfang et al. [17] showed that incorporating VCO into potato starch-based biodegradable film reduced WVTR and increased mechanical properties. Furthermore, Arifin et al. (2023) [18] reported that using VCO in corn starch-NCC nanocomposite film with various concentrations increased film elongation. Benedicta and Susanti reported that incorporating monoglyceride in cassava starch bioplastic could replace the functions of vegetable oils and emulsifiers [19]. These results underscore the need for more studies to determine the role of hydrophobic components including VCO and monoglyceride, which have different chemical structures in bionanocomposite film from other starch sources such as tubers.
This study has wide potential applications in various fields, such as environmentally friendly food packaging. The addition of hydrophobic components such as VCO and monoglyceride increases moisture resistance, making the film more suitable for packaging foods that require protection from humid air or liquids. Film can also be used as a biodegradable protective coating on fruits and vegetables that helps prolong freshness. In medical care, bionanocomposite film is used for disposable medical products as the material is biodegradable. Hydrophobic properties facilitate the use as a wrapper for cosmetic and pharmaceutical products that often require a barrier against water or moisture. This study is significant in addressing global plastic waste, empowering local resources, promoting sustainability and a circular economy, improving quality of life and ecological awareness, as well as innovating in renewable material.
Investigations on adding VCO and monoglyceride into bionanocomposite film are limited. Therefore, this study aimed to examine the differences in the effect of adding VCO and monoglyceride on the properties of EFY starch-NCC-based bionanocomposite film. In the experiment, a simple and effective casting method, easy to implement, requires renewable materials, does not cause waste and pollution to the environment was used, thereby supporting the circular economy and sustainability.
The materials used include carboxy methyl cellulose (Bratachem, Indonesia), dimodan distilled monoglyceride HP-M (PT. Berkat Karya Manna, Indonesia), distilled water, EFY (Brebes, Indonesia), NNC used was 471.3 nm obtained through microcrystalline cellulose Vivapur MCG 811 F purchased from Germany and processed by ball milling at PRINT-G Unpad, Indonesia. Other materials used include PP plastic, salt agar (SA) media, silica gel, sorbitol, tween 80 (Bratachem, Indonesia), and VCO (VIRJINT) from CV. Vermindo Internasional, Indonesia.
Starch was extracted from EFY in Brebes, East Java, Indonesia. The extraction method was determined in a previous study with slight modifications [20]. About 3 kg of peeled EFY was added to 12 L of water and crushed with a blender to reduce the size. Washing was performed several times until starch liquid was clear to obtain pure starch. The extraction was carried out by filtration of crushed tubers, and the filtrate was used for decantation for 24 h. Subsequently, the precipitate was dried in the oven at 50°C for 16 h. The dried starch was crushed with the grinder and sifted with an 80-mesh sieve.
VCO emulsion was prepared according to Sanjeewani [21], with slight modification. About 3 and 5 wt% of VCO, tween 80 based on 50% VCO weight, and 100 mL of aquadest were added to the glass beaker. The solution was mixed using a homogenizer for 5 min to create a stable emulsion. Subsequently, it was sonicated with an ultrasonic homogenizer for 5 min at 65% power.
2.4 Monoglyceride Solution Preparation
Monoglyceride solution was prepared according to Arifin et al. [18]. Distilled monoglyceride and 100 mL of aquadest were added to the glass beaker according to the concentration. The solution was stirred and heated using a hotplate stirrer until the temperature reached 70°C or monoglyceride melted. Subsequently, monoglyceride solution was sonicated for 5 min at 65% power to mix well.
2.5 Bionanocomposite Film Preparation
Bionanocomposite film was prepared according to Arifin et al. [18] with slight modification. About 3% w/v of EFY starch and 0.5% w/v of carboxymethyl cellulose (CMC) were placed into the glass beaker, then distilled water was added. The procedure continued with placing 5 wt% NCC into another beaker glass, and adding distilled water to achieve even dispersion. The NCC dispersion and the VCO emulsion or monoglyceride were poured into starch solution. Subsequently, the solution was mixed and heated using a hotplate stirrer until it reached 62°C before adding 2% v/v of sorbitol. This was followed by heating until the solution reached gelatinization temperature (about 82°C) where all ingredients reacted completely in film solution. Sonication was then carried out for 10 min at the power of 40%, then degassed for 15 min using an ultrasonic bath to remove air bubbles trapped in film matrix. Degassed film solution was poured into the casting plate with a size of 20 cm × 20 cm and dried at 50°C for 20 h. A flowchart of EFY bionanocomposite film production is presented in Fig. 1.

Figure 1: Flowchart of EFY bionanocomposite film production
2.6 Bionanocomposite Film Characterization
Following the method by Ratna et al. [22], the thickness of bionanocomposite film was measured using a micrometer with an accuracy of 0.01 mm. The measurement was carried out at five spots, including bionanocomposite film four edges and middle spots.
Film color was determined using the method proposed by Urland [23]. The measurement was carried out using a spectrophotometer CM 5 (Konica Minolta Co., Osaka, Japan) with Spectra Magic software. The instrument was calibrated using a zero-calibration plate (CM-A124) and white calibration plate (CM-A120), and the target was CM-A203. Bionanocomposite film test conducted was L* (lightness, 0 = black/100 = white), a* (+a* = red/−a* = green), b* (+b* = yellow/−b* = blue).
The solubility test was carried out following the method described by Jabraili et al. [24]. Bionanocomposite film was cut into a rectangle (2 cm × 2 cm), and dried in the oven at 105°C for 24 h. The dried sample was weighed to determine the dry weight (a) and immersed in 40 mL of distilled water for 24 h at 25°C. Filtration was then carried out through the filter paper (b) followed by drying in the oven at 105°C for 24 h to determine the final dry weight (c). The solubility was calculated using the equation:
where a = initial weight of dry sample; b = weight of filter paper; c = final weight of dry sample.
The water vapor transmission rate was measured according to ASTM E96 [25]. A glass jar was filled with 40% (w/v) sodium chloride to make it condition-saturated and stable at 75% RH. An aluminum cup with a diameter of 4 cm was filled with 10 g of silica gel, and the sample was placed over the surface of the cup. The cup was weighed every 8 h, and the weight loss was calculated. WVTR was calculated by determining the slope (g/h) and dividing by film area covering the cup.
where slope = humidity absorption every hour (g.h−1); A = area of film (m2).
Mechanical properties were determined according to ASTM D-882 [26]. The test used Universal Testing Machine UCT-5 T (Orientec Co. Ltd., Japan) with a 10 mm/min speed and a load cell of 10 kN. The sample condition preparation before testing was set at 23°C at 50% RH. Tensile strength, elongation, and Young’s modulus were calculated using the equation:
where σ = tensile strength (MPa); F = tensile force (N); A = area of the working force (mm2); ε = elongation (%); Δl = length increment; lo = initial sample length (cm); E = young’s modulus (MPa).
According to Nissa et al. [27], biodegradability refers to fungi degradation within a certain period. The media used was SA and Aspergillus niger, while samples were cut into a size of 1.5 cm × 1.5 cm and placed on the surface of SA in the petri dish. The sample was dripped with Aspergillus niger which had been diluted. On the 7th day, the photos of bionanocomposite film were processed using Image-J software to determine the degradation percentage.
Contact angle test was performed according to Abdullah et al. [28], by dripping distilled water onto the surface of bionanocomposite film. The water droplet on the surface was captured by Canon GX mark II and processed using Image-J to determine the formed contact angle.
2.6.8 FTIR (Fourier Transform Infrared Spectroscopy)
FTIR was characterized according to El Miri et al. [29] using a spectrophotometer (FTIR-thermo scientific nicolet iD5, Thermo Fisher Scientific Inc., Waltham, MA, USA). The sample was placed into the set holder, and the test was carried out in the 500 to 4000 cm−1 range.
2.6.9 SEM (Scanning Electron Microscope)
The morphology of bionanocomposite film was determined according to Jabraili et al. [24] using the SEM with Energy Dispersive X-ray System JEOL JSM-6360 LA (Tokyo, Japan). The sample was frozen with liquid nitrogen and cyrofractured before being coated with a thin conductive carbon layer.
The experimental data were statistically analyzed by One-way analysis of variance (ANOVA) using IBM SPSS Statistics 22.0. The experiments were repeated three times and Duncan’s multiple range test was used to evaluate significant differences between treatments at a significance level of 5% (p < 0.05).
Several factors can affect the thickness of film, including the total solid based on the addition of lipid concentration, the mold used, and the amount volume of bionanocomposite film solution. As shown in Table 1, there was an increment in thickness trend with increasing concentration, both VCO and monoglyceride. The highest thickness was 0.134 mm with the addition of 5 wt% monoglyceride. Similar results were obtained in a study conducted by Arifin et al. where bionanocomposite film was added with VCO at concentrations of 3 and 5 wt% [18].

The ANOVA test results on film thickness showed that the lipid addition in film was significantly different. The K0 treatment showed no significant differences from V3 but significantly lower than V5, M3, and M5. This was in line with Xiao et al. (2021), who explained that the increase in total solids occurred along with the addition of concentration [30]. Previous studies also reported the increment in thickness value due to the solid content of the sample [22]. This was presumably due to more material being dispersed in film matrix with a higher total solids content, thereby increasing the thickness. During the drying process, film with a higher solids content tended to shrink less because more solids were left behind as the water evaporated. The high solids content also increased the viscosity of film solution, which made it more difficult to spread thinly, leading to a thicker film when printed and dried. Meanwhile, the increase in lipid concentration did not significantly affect the thickness, probably because the concentration differences were minimal. The interaction between EFY starch as a polymer with NCC and lipids would reduce the movement of polymer chains and compression to form networks thereby increasing the thickness [31]. Based on the Japan Industrial Standard (JIS), the thickness value in this study fulfilled the required value of less than 0.25 mm [32].
Bionanocomposite film color is a significant parameter for consumer acceptance. The appearance representation is shown in Fig. 2. The L* value is a scale for measuring whiteness, where higher levels has a brighter film. The a* value correlates with redness (positive value) and greenness (negative value). The b* value correlates with yellowness (positive values) and blueness (negative values) [33].

Figure 2: The appearance of bionanocomposite film. Notes: K0 = 0 wt% lipid; V3 = 3 wt% VCO emulsion; V5 = 5 wt% VCO emulsion; M3 = 3 wt% monoglyceride; M5 = 5 wt% monoglyceride
The L* and a* ANOVA tests showed that lipid addition had a significant effect, while the b* test had no significant effect. Based on Table 2, the graph of the L* value in the VCO treatment showed an increment, and monoglyceride indicated a decrement. The increase in VCO concentration caused a brighter color, while the addition of monoglyceride concentration caused a darker color. This phenomenon has been reported by Arifin et al. on cornstarch-based bionanocomposite film where more addition of VCO increased the L* value [18]. However, increasing the VCO content caused a decrease in the L* value [34].

The V5 treatment had the highest L* value of 98.10 but was not significantly different from KO and V3 treatments. The decrease in L* value with a higher concentration of monoglyceride was in line with [35], who stated that adding oil emulsion into film caused the light to scatter, decreasing the L* value. However, this was in contrast to the results obtained by adding VCO. The increment in L* value on VCO addition was consistent with [18]. The study stated that VCO made the matrix polymer less compact and prevented starch crystallization, thereby increasing the L* value. Crystallization of starch could reduce the transparency of film.
The a* value showed fluctuations where the addition of VCO caused an increase at 3 wt% and a decrease at 5 wt% compared to KO. The addition of monoglyceride showed a lower value, with V3 having the highest value but not significantly different from K0 and V5. The addition of monoglyceride has a significant effect compared to KO. These results possibly occurred due to the characteristics of monoglyceride used, which tends to be clear when heated. Ho et al. [36] reported that palm oil, monoglyceride lipid component, was processed to make the color colorless. The b* value showed no significant differences with higher concentrations of VCO and monoglyceride. The decrease observed was presumably due to the small range of VCO and monoglyceride added. As described before, monoglyceride are colorless, while VCO is colorless yet turns yellowish when produced with excessive heat [37].
High-solubility film is not recommended as a packaging material with high water content, specifically for perishable food [35]. As shown in Table 1, the solubility decreased with the addition of lipids. This was in line with Sahraee et al. [38], where the addition of 10% N-chitin as a hydrophobic component reduced solubility.
The ANOVA test results showed that lipid composition had no significant effect on solubility. K0 had the highest solubility value, possibly because it did not contain lipids, hence, the hydroxyl groups as hydrophilic compounds caused interactions between starch and water [39]. The hydroxyl groups in starch structure were polar and acted as the primary interaction points with water through the formation of hydrogen bonds that facilitated the dispersion and solubilization of starch molecules in solution. This was the main mechanism that increased the solubility of nanocomposite film. The ANOVA test also showed that monoglyceride had the same effective ability as a hydrophobic component. Although the result did not significantly affect the solubility, adding lipids decreased the value. The increase in hydrogen bonding in the matrix polymer caused a decrease in the interaction of the matrix with free water, thereby reducing the solubility of bionanocomposite film [38]. Adding lipids to the treatments caused hydrophobic components to be dispersed and changed the polarity of film. The crystallinity was also affected, making film more resistant to water [33]. In this study, it was suspected that adding VCO and monoglyceride in the polymer matrix led to an interaction with non-polar or less polar polymer parts to form a hydrophobic phase. This was assumed to increase stronger internal hydrogen bonds between hydroxyl groups in the polymer chain around hydrophobic phase, making the polymer more resistant to water absorption and reducing the interaction of the matrix with free water. Consequently, the solubility of the nanocomposite film was reduced, making it more resistant to dissolution.
The fatty acid composition of the lipids might affect solubility. Generally, the difference in chain length determines hydrophobicity properties, making the lipids more water-resistant. VCO has lauric and myristic acid, with 12 and 14 carbon atoms. Hydrogenated palm, as the source of monoglyceride, has 15 and 17 carbon atoms [19]. Crépy et al. [40] also stated that the length of the fatty chain affected hydrophobic properties of cellulose fatty esters plastics.
Bionanocomposite film intended for packaging requires good mechanical properties. Table 3 presents the results of the mechanical properties test. The ANOVA test results showed significantly different values for tensile strength, elongation, and Young’s modulus.

The tensile strength value showed a decrease with the addition of VCO and monoglyceride. This result was in line with a previous study conducted by Xiao et al. [41] and Binsi et al. [34], who reported that the addition of lipids led to decreased tensile strength values in film. Although adding VCO and monoglyceride significantly impacted tensile strength, the 3 wt% VCO did not differ significantly from KO. Based on the results, K0 had the highest tensile strength significance at 4.88 ± 0.10 MPa. This outcome was attributed to the favorable interaction between the polymer matrix and nanoparticles, as shown by Abdul Khalil et al. [42]. Conversely, M5 showed the significantly lowest tensile strength compared to other treatments.
The presence of lipids in this study led to diminished tensile strength, with a significant reduction as lipid concentration increased. This phenomenon was attributed to the aggregation of lipid droplets, disrupting intermolecular hydrogen bond interactions within the polymer matrix. The incorporation of lipids creates free volume within film structure, compromising the polymer matrix integrity and reducing tensile strength [43]. The length of the fatty acid chain could also affect these results. A previous study stated that as the length of the fatty acid and saturation, film becomes more elastic [40]. Medium to long-chain fatty acid molecules in VCO and monoglyceride presumably have flexible structures and could act as lubricants in the polymer matrix of film [44]. These fat molecules fill the spaces between polymer molecules and allow the chains to move more freely. With this “lubrication”, film matrix could experience greater strain without breaking, thereby increasing the elongation value. The schematic reaction of EFY bionanocomposite film is presented in Fig. 3.

Figure 3: Schematic reaction of EFY bionanocomposite film
The elongation value showed an incremental rise in values. However, fluctuation was observed, where incorporating VCO and monoglyceride led to increased elongation at 3 wt% and a subsequent decrease at 5 wt%. This was different from the results of Binsi et al. [34], who suggested that higher VCO concentrations should correlate with increased percent elongation. Xiao et al. [41] showed an increment of elongation as the VCO concentration increased, followed by a decrease. K0 had the lowest significance, while M3 showed the highest significance at 90.74 ± 8.10%. This phenomenon can be attributed to the absence of added lipids in KO sample, resulting in a lower occurrence of the plastic effect. Adding lipids enhanced elongation values, but elevating the concentration appeared to diminish elongation. This effect might be attributed to the significant lipid concentration causing agglomeration, making film more prone to fracture [17].
In line with the trend observed in tensile strength, Young’s modulus value decreased as lipids were introduced and concentrations increased. The highest significance was attributed to K0, recording a value of 0.07 ± 0.00 MPa, although not significantly different from V3, V5, and M3. The M5 treatment showed the lowest significant value at 0.048 MPa. There was a downward trend in Young’s modulus value with the inclusion of lipids and escalating concentration. This outcome can be attributed to the decrement of tensile strength, resulting in elevated elongation values and, consequently, a reduction in Young’s modulus values. Furthermore, an increment of Young’s modulus shows enhanced rigidity. K0 had the highest significance from the absence of additional lipids that could otherwise function as plasticizers [34]. Based on JIS, the tensile strength and elongation values were still within the standard, above 0.39 MPa and 70% respectively [32].
Water vapor tends to diffuse on the matrix with the amorphous surface. The permeability of film is influenced by the degree of crystallinity, with increased crystallinity leading to a reduction in hydrophilic groups [38,45]. The trend in Table 1 showed decreasing WVTR values with the addition of lipids at various concentrations, and the ANOVA test confirmed the significant impact of lipid addition. Decreasing WVTR values with the addition of lipids was also observed by Binsi et al. [34]. Similarly, Xiao et al. [41] reported a corresponding effect, with higher concentrations of VCO leading to reduced water vapor permeability in film incorporating glucomannan, agar, and gum arabic.
As shown in Table 1, K0 had a significant difference with the inclusion of 5% monoglyceride (M5), although no significant differences were observed compared to VCO treatments. M5 showed the lowest level of significance among all treatments. The reduction in WVTR value was attributed to the addition of lipid that function as a hydrophobic and nonpolar element [43]. The amylose in EFY starch forms starch-lipid complex, leading to elevated structural integrity and increased hydrophobic characteristics with higher lipid concentrations [17]. The addition of monoglyceride led to a lower WVTR value compared to VCO. This observation was likely due to the elongated chain length of fatty acids in monoglyceride, enhancing hydrophobic properties [19].
Monoglyceride have hydrophilic and lipophilic groups, enabling a more stable interaction between the hydrophilic component of the matrix polymer and hydrophobic constituents, namely fatty acids monoglyceride [46]. Conversely, VCO emulsion is often unstable during drying, thereby requiring favorable stability. This stability is crucial for forming a compact film matrix [34]. The addition of NCC within the polymer matrix elevated the presence of intermolecular hydrogen bonds, reducing hydrophilic groups [38]. These bonds caused a tortuous film structure, reducing water vapor diffusion efficiency [47]. According to JIS, the WVTR value of bionanocomposite film evaluated was still within the standard below 7 g.m−2.h−1 [32].
Bionanocomposite film made of organic polymers is often easy to degrade. Hydroxyl and carbonyl groups within these polymers increase susceptibility to breakdown by naturally occurring microorganisms [48]. This is presumably because hydroxyl and carbonyl groups are polar, easily interacting with water molecules and enzymes produced by microorganisms [49]. This polarity allows microbial enzymes to attach and recognize reactive sites in the polymer structure. Considering hydroxyl and carbonyl groups can attract enzyme and water molecules, biochemical reactions triggered by enzymes such as hydrolases or oxidases become easier in these groups, accelerating the decomposition process. According to [50], fungi play an essential role in biodegradable plastics by secreting several degrading enzymes, namely cutinase, lipase, protease, lignocellulolytic enzymes, and several pro-oxidant ions, which cause effective degradation. The oxidation or hydrolysis process of enzymes degrades polymers from high to low molecular weight due to the production of functional groups with high polymer hydrophilicity properties. Other factors, such as the ease of hydrogen bond formation, accessibility in the polymer structure, and the ability to attract moisture, make it easier for microbial enzymes to recognize and break down the polymer structure, accelerating the biodegradation process. The decomposition of biodegradable materials is facilitated by microorganisms and other natural parameters [51]. This was supported by experimental studies by Shalem et al. [52] who investigated the enzymatic degradation of natural PLA-based bioplastics using various enzymes isolated and purified from degrading microorganisms. Table 4 presents the result of biodegradability obtained in this study.

Table 4 and Fig. 4 show that degradation declined with the addition of VCO and monoglyceride. This trend of reduced degradation was consistent with the study by Suryadinata et al. [53], who explored bacterial cellulose-polyethylene glycol-based biodegradable plastics added with VCO. Biodegradability ANOVA showed statistically significant differences among the outcomes. K0 had the highest significance at 86.21%, potentially attributed to the comparatively greater hydrophilic properties than the other treatments. The addition of lipids at varying concentrations reduced biodegradability, where V5 and M5 showed the least significance and did not have significant differentiation. Similar patterns were observed for V3, which did not have significant differentiation to M3 and K0. The similarity in the degree of degradation was due to the addition of equal concentrations of VCO and monoglyceride.
Figure 4: Biodegradability test results of bionanocomposite film on the 7th day. Note: K0 = 0 wt% lipid; V3 = 3 wt% VCO emulsion; V5 = 5 wt% VCO emulsion; M3 = 3 wt% monoglyceride; M5 = 5 wt% monoglyceride
The similarity in the degree of degradation resulted from hydrophobic nature of VCO and monoglyceride, making both less able to interact with water. However, this study also showed a slightly diminished value in addition to VCO compared to monoglyceride. The occurrence was presumed from VCO lauric acid content, provided with antimicrobial properties capable of inhibiting the degradation of bionanocomposite film [17].
According to Xu et al. [54], surface characterization uses a contact angle measurement to distinguish hydrophobic and hydrophilic properties. An angle that exceeds 90° signifies hydrophobicity, while a measurement below 90° suggests hydrophilicity. As shown in Fig. 5, K0 had an elevated contact angle value, potentially attributed to the presence of NCC within the polymer matrix. This inclusion augments intermolecular hydrogen bonding, and bionanocomposite film tends to be more hydrophobic, as shown by Sahraee et al. [38]. The effect observed can be attributed to NCC substantial crystallinity, as mentioned by Ma et al. [55]. The high degree of contact angle at M5 was due to the incorporation of lipids, recognized as a hydrophobic component by Barrino et al. [56]. These results were in line with the outcomes of Abdullah et al. [28], where the addition of 5% palm oil elevated the contact angle from 45.95° to 61.98°.

Figure 5: Contact angle of bionanocomposite film of (a) K0 and (b) M5. Note: K0 = 0 wt% lipid; M5 = 5 wt% monoglyceride
Hydrophobicity presumably plays an important role in slowing down the degradation of nanocomposite film (Table 4) by reducing water absorption, blocking the penetration of enzymes and microorganisms, as well as slowing down the hydrolysis reaction in the polymer matrix. Consequently, more hydrophobic film have better resistance to humid environmental conditions, making the degradation rate lower than that of hydrophilic film [57].
Fig. 6 shows alterations in peak wavenumber, indicating shifts in chemical bonds attributed to the addition of monoglyceride. The results showed a slight reduction in wavenumber during O-H stretching, shifting from 3282 to 3278 cm−1 upon the addition of 5% monoglyceride. This observation showed an interaction between starch and monoglyceride facilitated by hydrogen bonding. A decrease in the peak wavenumber might also show a decline in the hydroxyl groups of EFY starch [33]. Syafiq et al. [58] and Asad et al. [59] reported a different result where an elevation in the concentration of cinnamon essential oil led to an increase in wavenumber for O-H stretching. This trend was attributed to the presence of hydrocarbon groups in the oil. The nanocomposite film hydrophilic nature shows the O-H groups and the results from FT-IR analysis provided evidence that K0 had greater hydrophilic properties than M5.

Figure 6: FTIR absorption of bionanocomposite film of KO (0 wt% lipid) and M5 = 5 wt% monoglyceride
Fig. 6 also shows the shift in the peak from wavenumber 2924 to 2927 cm−1. Asad et al. stated that the high peak in the 2900–3100 cm−1 wavenumber range showed the aliphatic chain symmetric and asymmetric C-H stretching [59]. The presence of the peak was also in line with the study by Xiao et al. [41], where C-H groups correlated with saturated fatty acid chains on film incorporated VCO. A peak appeared at the wavenumber of 2115 cm−1 in both K0 and M5, corresponding to the C=C groups [60]. FTIR spectrum wavenumber of bionanocomposite film is shown in Table 5.

The wavenumbers of 1623 and 1633 cm−1 in both K0 and M5 showed that incorporating monoglyceride increased the presence of C=O groups originating from the fatty acids. Consequently, the M5 showed increased hydrophobicity [44]. The peaks corresponding to the wavenumber of 1014 and 1004 cm−1 in both K0 and M5 showed a correlation with the C-O group, which could be attributed to the plasticizer and polysaccharide components [18]. The peaks in K0 and M5, as shown in Fig. 6, were similar to the previous study by Xiao et al. [41] and Syafiq et al. [58] with the incorporation of VCO and cinnamon essential oil.
Fig. 7 shows the surface morphology of bionanocomposite film, with Fig. 7a showing the presence of spherical formations suspected to be starch granules. These granules resulted from the gelatinization process in the fabrication of bionanocomposite film. The process requires refined starch, water, and a heating step, as mentioned by Abdullah et al. [28] who investigated starch-based bioplastics incorporated with palm oil. In the absence of added oil in K0, visible starch granules adopted a sharp, rounded shape, while Fig. 7b shows a diverse morphology compared to K0. This variance could be attributed to the addition of monoglyceride lipids. Abdullah et al. [28] reported that including palm oil led to irregular starch granule shapes.

Figure 7: SEM micrographs of bionanocomposite film of (a) K0 and (b) M5. Note: K0 = 0 wt% lipid; M5 = 5 wt% monoglyceride
Fig. 7b shows the treatment involving the addition of 5% monoglyceride. In this case, starch granules appeared more irregular and compact than in Fig. 7a. This alteration was attributed to the bonding between starch and lipids induced by the lipid addition. Moreover, the visibly rougher surface was more cohesive, as also reported in a study conducted by Arifin et al. [18]. It was reported that incorporating lipids (VCO) led to a weak interaction between lipids and the polymer matrix. Lian et al. [61] stated that the addition of thyme essential oil caused an increase in roughness on the surface and cross-section of film, as also reported by Abdul Khalil et al. [42]. According to Xiao et al. [41], the heating process facilitates the migration of unstable lipids towards film surface. This phenomenon leads to an elevated lipid concentration on the surface, thereby inducing matrix inhomogeneity. In this study, monoglyceride were considered to help distribute lipids into bionanocomposite film matrix by reducing the intermolecular bonds of starch, thereby reducing the intensity of starch and NCC crystal peaks, making it more likely to form an amorphous structure. Monoglyceride acted as plasticizers that could increase the mobility of polymer chains, making it more difficult for molecules to form a rigid crystalline structure [41]. This could broaden the X-ray diffraction (XRD) peaks and increase the amorphous area in the material. In these samples, monoglyceride might show small diffraction peaks depending on the concentration and degree of crystallinity. The addition of VCO and monoglyceride affected the crystallization of EFY starch and NCC in the nanocomposite film, affecting the physical and mechanical properties (Table 3). This was in line with the study conducted by Gao et al. [44], where the crystal peak disappeared in corn starch/octenyl succinate composite film added with various concentrations of soybean oil. The result showed that all film had significantly lower crystallinity and a more amorphous structure.
In conclusion, EFY-NCC starch-based bionanocomposite film with the addition of VCO and monoglyceride was successfully prepared using the solution casting method. The impact of monoglyceride addition on bionanocomposite film surpassed that of VCO, significantly affecting the composite properties. Compared to VCO, the addition of monoglyceride had more effect on increasing thickness and elongation, as well as decreasing solubility and WVTR. Meanwhile, VCO had better values in terms of color, tensile strength, and Young’s modulus. The addition of 5% monoglyceride produced the best results among the other treatments, causing a reduction in the WVTR value to 3.99 g.m−2.h−1, the degree of biodegradability to 63.67%, the solubility value to 36.04%, but increased hydrophobicity to 95.35° due to the role as a hydrophobic agent. Although the tensile strength and Young’s modulus decreased with the addition of monoglyceride, the elongation increased to 74.59% due to the role as a lubricant in the composite matrix. The interaction of monoglyceride with starch granules and NCC in the composite matrix resulted in the appearance of softer granules. FTIR tests confirmed the presence of elongated wavelengths for C=O groups and reduced intensity for O-H groups. Based on these results, the use of sustainable materials in the manufacture of bionanocomposite film has great opportunities in the application as food packaging that can replace conventional fossil-based plastics.
Acknowledgement: Universitas Padjadjaran, Bandung, Indonesia, financially supported this study.
Funding Statement: This study was funded by an Internal Research Grant of Universitas Padjadjaran, Bandung, Indonesia.
Author Contributions: Heni Radiani Arifin: Project administration, Supervision, Writing—review & editing; Yoan Christina Angelica: Conceptualization, Investigation, Writing—original draft; Bambang Nurhadi: Supervision, Methodology, Validation; Herlina Marta: Supervision, Validation; Rossy Choerun Nissa: Resources, Methodology. All authors reviewed the results and approved the final version of the manuscript.
Availability of Data and Materials: All data generated or analyzed during the current study are available from the corresponding author upon reasonable request.
Ethics Approval: Not applicable.
Conflicts of Interest: The authors declare no conflicts of interest to report regarding the present study.
References
1. Muhammad M, Ridara R, Masrullita M. Synthesis of bioplastic from avocado seed starch with chitosan filler. J Teknol Kim. 2020;9(2):1–11. doi:10.29103/jtku.v9i2.3340. [Google Scholar] [CrossRef]
2. Saputro ANC, Ovita AL. Synthesis and characterization of bioplastic from Chitosan-Ganyong Starch (Canna edulis). JKPK (Jurnal Kim Pendidik Kim). 2017;2(1):13. doi:10.20961/jkpk.v2i1.8526. [Google Scholar] [CrossRef]
3. Li Y, Tao L, Wang Q, Wang F, Li G, Song M. Potential health impact of microplastics: a review of environmental distribution, human exposure, and toxic effects. Environ Heal. 2023;1(4):249–57. doi:10.1021/envhealth.3c00052. [Google Scholar] [PubMed] [CrossRef]
4. Dawam Abdullah AH, Fikriyyah AK, Furghoniyyah U. Effect of chitin addition on water resistance properties of starch-based bioplastic properties. IOP Conf Ser Earth Environ Sci. 2020;483(1):012002. doi:10.1088/1755-1315/483/1/012002. [Google Scholar] [CrossRef]
5. Merino D, Zych A, Athanassiou A. Biodegradable and biobased Mulch film: highly stretchable PLA composites with different industrial vegetable waste. ACS Appl Mater Interfaces. 2022;14(41):46920–31. doi:10.1021/acsami.2c10965. [Google Scholar] [PubMed] [CrossRef]
6. Paudel S, Regmi S, Janaswamy S. Effect of glycerol and sorbitol on cellulose-based biodegradable film. Food Package Shelf. 2023;37:101090. doi:10.1016/j.fpsl.2023.101090. [Google Scholar] [CrossRef]
7. Priyadarshi R, Rhim JW. Chitosan-based biodegradable functional film for food packaging applications. Innov Food Sci Emerg Technol. 2020;62:102346. doi:10.1016/j.ifset.2020.102346. [Google Scholar] [CrossRef]
8. Harrazi N, Özbek HN, Yanık DK, Zaghbib I, Göğüş F. Development and characterization of gelatin-based biodegradable film incorporated with pistachio shell hemicellulose. J Food Sci Technol. 2024;61(10):1919–29. doi:10.1007/s13197-024-05968-4. [Google Scholar] [PubMed] [CrossRef]
9. Yang J, Ching YC, Sabariah Julai J, Chuah CH, Nguyen DH, Lin PC. Comparative study on the properties of starch-based bioplastics incorporated with palm oil and epoxidized palm oil. Polym Polym Compos. 2022;30:1–11. doi:10.1177/09673911221087595. [Google Scholar] [CrossRef]
10. Widiastuti ES, Rosyidi D, Radiati LE, Purwadi P. The effect of elephant foot Yam (Amorphophallus campanulatus) flour and soybean oil addition on the physicochemical and sensory properties of beef sausage. J Ilm Teknol Has Ternak. 2020;15(2):119–30. doi:10.21776/ub.jitek.2020.015.02.7. [Google Scholar] [CrossRef]
11. Abe MM, Martins JR, Sanvezzo PB, Macedo JV, Branciforti MC, Halley P, et al. Advantages and disadvantages of bioplastics production from starch and lignocellulosic components. Polymers. 2021;13(15):2484. doi:10.3390/polym13152484. [Google Scholar] [PubMed] [CrossRef]
12. Shchipunov Y. Bionanocomposite: green sustainable materials for the near future. Pure Appl Chem. 2012;84(12):2579–607. doi:10.1351/PAC-CON-12-05-04. [Google Scholar] [CrossRef]
13. Arifin HR, Djali M, Nurhadi B, Hasim SA, Hilmi A, Puspitasari AV. Improved properties of corn starch-based bio-nanocomposite film with different types of plasticizers reinforced by nanocrystalline cellulose. Int J Food Prop. 2022;25(1):509–21. doi:10.1080/10942912.2022.2052085. [Google Scholar] [CrossRef]
14. Taib MNAM, Yehye WA, Julkapli NM, Hamid SBOAA. Influence of hydrophobicity of acetylated nanocellulose on the mechanical performance of Nitrile Butadiene Rubber (NBR) composites. Fibers Polym. 2018;19(2):383–92. doi:10.1007/s12221-018-7591-z. [Google Scholar] [CrossRef]
15. Gustafsson J, Landberg M, Bátori V, Åkesson D, Taherzadeh MJ, Zamani A. Development of bio-based film and 3D objects from apple pomace. Polymers. 2019;11(2):289. doi:10.3390/polym11020289. [Google Scholar] [PubMed] [CrossRef]
16. Safitri N, Rahmaniah I. Quality study of biodegradable plastic film based on waxy corn starch (Zea Mays Ceratina) with the addition of chitosan and Virgin Coconut Oil (VCO). J Fis Ter. 2021;8:65–72. doi:10.24252/jft.v8i1.21211. [Google Scholar] [CrossRef]
17. Fangfang Z, Xinpeng B, Wei G, Wang G, Shi Z, Jun C. Effects of virgin coconut oil on the physicochemical, morphological and antibacterial properties of potato starch-based biodegradable film. Int J Food Sci Technol. 2020;55(1):192–200. doi:10.1111/ijfs.14262. [Google Scholar] [CrossRef]
18. Arifin HR, Utaminingsih F, Djali M, Nurhadi B. The role of virgin coconut oil in corn Starch/NCC-based nanocomposite film matrix: physical, mechanical, and water vapor transmission characteristics. Polymers. 2023;15:1–13. doi:10.3390/polym15153239. [Google Scholar] [PubMed] [CrossRef]
19. Benedicta PP, Sutanti S. Effect of vegetable oil monoglyceride addition on mechanical properties of Tapioca Bioplastic. J Ilm Tek Kim. 2021;5(2):71. doi:10.18697/ajfand.69.15015. [Google Scholar] [CrossRef]
20. Safitri ELD, Warkoyo W, Anggriani R. Study of physical and mechanical characteristics of edible film based on Suweg Tuber Starch (Amorphophallus paeoniifolius) with variation of Beeswax concentration. Food Technol Halal Sci J. 2020;3(1):57. doi:10.17582/journal.sja/2021.37.s1.144.152. [Google Scholar] [CrossRef]
21. Sanjeewani A, Sakeena F. Formulation and characterization of Virgin Coconut Oil (VCO) based emulsion. Int J Sci Res Publ. 2013;3(12):1–6. [Google Scholar]
22. Ratna, S,Aprilia, R, Arahman N, Bilad MR, Suhaimi H, Munawar AA, et al. Bio-nanocomposite based on Edible Gelatin film as active packaging from Clarias gariepinus fish skin with the addition of cellulose nanocrystalline and nanopropolis. Polymers. 2022;14(18):3738. doi:10.3390/polym14183738. [Google Scholar] [PubMed] [CrossRef]
23. Urland A. Colour specification and measurement. In: ARC laboratory handbook. Rome, Italy: ICCROM; 1999. [Google Scholar]
24. Jabraili A, Pirsa S, Pirouzifard MK, Amiri S. Biodegradable nanocomposite film based on Gluten/Silica/Calcium Chloride: physicochemical properties and bioactive compounds extraction capacity. J Polym Environ. 2021;29(8):2557–71. doi:10.1007/s10924-021-02050-4. [Google Scholar] [CrossRef]
25. Labthink. An outline of standard ASTM E96 for cup method water vapor permeability testing; 2016 [cited 2024 Nov 10]. p. 1–6. Available from: http://en.labthink.com/en-us/literatures/an-outline-of-standard-for-cup-method-water-vapor-permeability-testing.html. [Google Scholar]
26. ASTM. Standard test method for tensile properties of thin plastic sheeting (D882). In: Annual book of ASTM standards. Philadelpia: American Society for Testing and Material; 2012. [Google Scholar]
27. Nissa RC, Fikriyyah AK, Abdullah AHD, Pudjiraharti S. Preliminary study of biodegradability of starch-based bioplastics using ASTM G21-70, dip-hanging, and Soil Burial Test methods. IOP Conf Ser Earth Environ Sci. 2019;277(1):012007. doi:10.1088/1755-1315/277/1/012007. [Google Scholar] [CrossRef]
28. Abdullah AHD, Fikriyyah AK, Dewantoro R. Fabrication and characterization of starch based bioplastics with palm oil addition. J Mater Sci. 2019;20:126–31. doi:10.17146/jsmi.2019.20.3.4846. [Google Scholar] [CrossRef]
29. El Miri N, Abdelouahdi K, Zahouily M, Fihri A, Barakat A, Solhy A, et al. Bio-nanocomposite film based on cellulose nanocrystals filled polyvinyl alcohol/chitosan polymer blend. J Appl Polym Sci. 2015;132(22):1–13. doi:10.1002/app.42004. [Google Scholar] [CrossRef]
30. Xiao M, Tang B, Qin J, Wu K, Jiang F. Properties of film-forming emulsions and film based on corn starch/sodium alginate/gum Arabic as affected by virgin coconut oil content. Food Packag Shelf. 2022;32:100819. doi:10.1016/j.fpsl.2022.100819. [Google Scholar] [CrossRef]
31. Zhang YP, Wang X, Shen Y, Thakur K, Zhang JG, Hu F, et al. Preparation and characterization of bio-nanocomposites film of chitosan and montmorillonite incorporated with ginger essential oil and its application in chilled beef preservation. Antibiotics. 2021;10(7):796. doi:10.3390/antibiotics10070796. [Google Scholar] [PubMed] [CrossRef]
32. JIS. Japanese Industrial Standard Z 1707. Tokyo: Japanese Standards Association; 1975. [Google Scholar]
33. Issa AT, Schimmel K, Worku M, Shahbazi A, Salam AIRT. Sweet Potato Starch-based nanocomposites: development, characterization, and biodegradability. Starch/Staerke. 2018;70:7–8. doi:10.1002/star.201700273. [Google Scholar] [CrossRef]
34. Binsi PK, Ravishankar CN, Gopal TKS. Development and characterization of an edible composite film based on chitosan and virgin coconut oil with improved moisture sorption properties. J Food Sci. 2013;78(4):E526–34. doi:10.1111/1750-3841.12084. [Google Scholar] [PubMed] [CrossRef]
35. Ghasemlou M, Aliheidari N, Fahmi R, Shojaee-Aliabadi S, Keshavarz B, Cran MJ, et al. Physical, mechanical and barrier properties of corn starch film incorporated with plant essential oils. Carbohydr Polym. 2013;98(1):1117–26. doi:10.1016/j.carbpol.2013.07.026. [Google Scholar] [PubMed] [CrossRef]
36. Ho CC, Chow MC. Effect of the refining process on the interfacial properties of palm oil. J Am Oil Chem Soc. 2000;77(2):191–9. doi:10.1007/s11746-000-0031-7. [Google Scholar] [CrossRef]
37. Abujazia MA, Muhammad N, Shuid AN, Soelaiman IN. The effects of virgin coconut oil on bone oxidative status in ovariectomised rat. Evid-Based Complement Altern Med. 2012;2012(3):837–45. doi:10.1155/2012/525079. [Google Scholar] [PubMed] [CrossRef]
38. Sahraee S, Milani J, Ghanbarzadeh B, Hamishehkar H, Kafil HS. Physicochemical and antifungal properties of bio-nanocomposite film based on gelatin-chitin nanoparticles. Int J Biol Macromol. 2016. doi:10.1016/j.ijbiomac.2016.12.066. [Google Scholar] [PubMed] [CrossRef]
39. Zarski A, Kapusniak K, Ptak S, Rudlicka M, Coseri S, Kapusniak J. Functionalization methods of Starch and its derivatives: from old limitations to new possibilities. Polymers. 2024;16(5):1–46. doi:10.3390/polym16050597. [Google Scholar] [PubMed] [CrossRef]
40. Crépy L, Chaveriat L, Banoub J, Martin P, Joly N. Synthesis of cellulose fatty esters as plastics-influence of the degree of substitution and the fatty chain length on mechanical properties. ChemSusChem. 2009;2(2):165–70. doi:10.1002/cssc.200800171. [Google Scholar] [PubMed] [CrossRef]
41. Xiao M, Luo L, Tang B, Qin J, Wu K, Jiang F. Physical, structural, and water barrier properties of emulsified blend film based on konjac glucomannan/agar/gum Arabic incorporating virgin coconut oil. LWT-Food Sci Technol. 2022;154:112683. doi:10.1016/j.lwt.2021.112683. [Google Scholar] [CrossRef]
42. Abdul Khalil HPS, Tye YY, Ismail Z, Leong JY, Saurabh CK, Lai TK, et al. Oil palm shell nanofiller in seaweed-based composite film: mechanical, physical, and morphological properties. BioResources. 2017;12(3):5996–6010. doi:10.5555/20173337666. [Google Scholar] [CrossRef]
43. Farajpour R, Emam Djomeh Z, Moeini S, Tavahkolipour H, Safayan S. Structural and physico-mechanical properties of potato starch-olive oil edible film reinforced with zein nanoparticles. Int J Biol Macromol. 2020;149:941–50. doi:10.1016/j.ijbiomac.2020.01.175. [Google Scholar] [PubMed] [CrossRef]
44. Gao W, Wu W, Liu P, Hou H, Li X, Cui B. Preparation and evaluation of hydrophobic biodegradable film made from corn/octenylsuccinated starch incorporated with different concentrations of soybean oil. Int J Biol Macromol. 2020;142:376–83. doi:10.1016/j.ijbiomac.2019.09.108. [Google Scholar] [PubMed] [CrossRef]
45. Khan A, Khan RA, Salmieri S, Le Tien C, Riedl B, Bouchard J, et al. Mechanical and barrier properties of nanocrystalline cellulose reinforced chitosan based nanocomposite film. Carbohydr Polym. 2012;90(4):1601–8. doi:10.1016/j.carbpol.2012.07.037. [Google Scholar] [PubMed] [CrossRef]
46. Setyaningsih D, Suraya J, Salsabila S. The effects of Mono-Acylglycerol (Mag) addition as emulsifiers of bakery product. J Teknol Ind Pertan. 2021;31(2):198–210. doi:10.24961/j.tek.ind.pert.2021.31.2.198. [Google Scholar] [CrossRef]
47. Huq T, Salmieri S, Khan A, Khan RA, Le Tien C, Riedl B, et al. Nanocrystalline cellulose (NCC) reinforced alginate based biodegradable nanocomposite film. Carbohydr Polym. 2012;90(4):1757–63. doi:10.1016/j.carbpol.2012.07.065. [Google Scholar] [PubMed] [CrossRef]
48. Hamzah FH, Sitompul FF, Ayu DF, Pramana A. Effect of the glycerol addition on the physical characteristics of biodegradable plastic made from oil palm empty fruit bunch. Ind J Teknol Manaj Agroindustri. 2021;10(3):239–48. doi:10.21776/ub.industria.2021.010.03.5. [Google Scholar] [CrossRef]
49. Facciotti MT. Nonpolar functional groups Polar functional groups. The LibreTexts libraries. California: California State University Affordable Learning Solutions Program, and Merlot; 2021. p. 2–7. [Google Scholar]
50. Srikanth M, Sandeep TSRS, Sucharitha K, Godi S. Biodegradation of plastic polymers by fungi: a brief review. Bioresour Bioprocess. 2022;9(1):547. doi:10.1186/s40643-022-00532-4. [Google Scholar] [PubMed] [CrossRef]
51. Ghimire S. Investigating the biodegradability of hydrophobic bio-based materials [Internet]. Arcada; 2023 [cited 2024 Nov 10]. Available from: https://www.theseus.fi/bitstream/handle/10024/805032/Ghimire_Sapana.pdf?sequence=2. [Google Scholar]
52. Shalem A, Yehezkeli O, Fishman A. Enzymatic degradation of polylactic acid (PLA). Appl Microbiol Biotechnol. 2024;108(1):2581. doi:10.1007/s00253-024-13212-4. [Google Scholar] [PubMed] [CrossRef]
53. Suryadinata A, Putra A. Mechanical properties and biodegradation of biodegradable plastic based on bacterial cellulose-Polyethylene Glycol (PEG) from coconut water (Cocos nucifera) incorporating Virgin Coconut Oil (VCO). J Period Jur Kim UNP. 2023;12(1):22. doi:10.1016/j.bioadv.2022.213139. [Google Scholar] [CrossRef]
54. Xu J, Xia R, Yuan T, Sun R. Use of xylooligosaccharides (XOS) in hemicelluloses/chitosan-based film reinforced by cellulose nanofiber: effect on physicochemical properties. Food Chem. 2019;298:125041. doi:10.1016/j.foodchem.2019.125041. [Google Scholar] [PubMed] [CrossRef]
55. Ma Q, Hu D, Wang L. Preparation and physical properties of tara gum film reinforced with cellulose nanocrystals. Int J Biol Macromol. 2016;86:606–12. doi:10.1016/j.ijbiomac.2016.01.104. [Google Scholar] [PubMed] [CrossRef]
56. Barrino F, De La Rosa-Ramírez H, Schiraldi C, López-Martínez J, Samper MD. Preparation and characterization of new bioplastics based on Polybutylene Succinate (PBS). Polymers. 2023;15(5):1–15. doi:10.3390/polym15051212. [Google Scholar] [PubMed] [CrossRef]
57. Alahmed A, Simsek S. Improving biodegradable film from corn bran arabinoxylan for hydrophobic material and green food packaging. Foods. 2024;13(12):1–16. doi:10.3390/foods13121914. [Google Scholar] [PubMed] [CrossRef]
58. Syafiq R, Sapuan SM, Zuhri MRM. Antimicrobial activity, physical, mechanical and barrier properties of sugar palm based nanocellulose/starch biocomposite film incorporated with cinnamon essential oil. J Mater Res Technol. 2021;11:144–57. doi:10.1016/j.jmrt.2020.12.091. [Google Scholar] [CrossRef]
59. Asad M, Saba N, Asiri AM, Jawaid M, Indarti E, Wanrosli WD. Preparation and characterization of nanocomposite film from oil palm pulp nanocellulose/poly (Vinyl alcohol) by casting method. Carbohydr Polym. 2018;191:103–11. doi:10.1016/j.carbpol.2018.03.015. [Google Scholar] [PubMed] [CrossRef]
60. Ujuldah A, Hakim AR, Saputri R. FTIR spectroscopic characterization of edible bird’s nest from jenamas central kalimantan. Int J Pharm Appl Heal Sci. 2023;1(1):1–5. doi:10.1038/s41598-023-41851-6. [Google Scholar] [CrossRef]
61. Lian H, Peng Y, Shi J, Wang Q. Effect of emulsifier hydrophilic-lipophilic balance (HLB) on the release of thyme essential oil from chitosan film. Food Hydrocoll. 2019;97:105213. doi:10.1016/j.foodhyd.2019.105213. [Google Scholar] [CrossRef]
Cite This Article
Copyright © 2025 The Author(s). Published by Tech Science Press.This work is licensed under a Creative Commons Attribution 4.0 International License , which permits unrestricted use, distribution, and reproduction in any medium, provided the original work is properly cited.


Submit a Paper
Propose a Special lssue
View Full Text
Download PDF
Downloads
Citation Tools